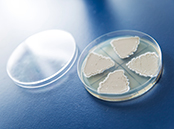
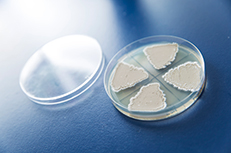
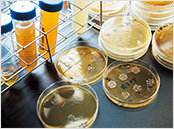
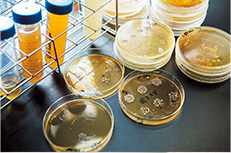

学びのスタイル


理工学研究科 化学生命工学専攻
博士課程前期課程 1年次生
小林 彩乃
研究テーマ
心臓形成に関わる遺伝子の機能解析



心臓は動物の多くがもつ重要な器官ですが、人間の新生児のうち100人に1人が心臓に何らかの異常をもっているとされています。その原因の一つとして、心臓の形成に関与する遺伝子の変異が考えられますが、そのメカニズムは未だに不明です。私は、人間よりも心臓の構造が単純なメダカを用いて、心臓形成に関わる遺伝子の機能を解析し、人間の先天的な心疾患を減らすことを目標に研究を行っています。研究の中で、人間の心臓関連の遺伝子がメダカの心臓でも存在しているかを確認するのですが、先行実験と同様の進め方をしても失敗することがあります。トライアンドエラーを繰り返す中で、「なぜ失敗したのか」を考えることで、問題のありかを把握する力が身に付いたと感じます。
この学科を選んだ理由
高校時代の授業がきっかけで化学が好きになり、特に生き物の生命活動に関わる化学現象について学びたいと思い、この学科を選びました。
将来の目標
大学院で研究を続けた上で、その経験をもとに遺伝子治療などの医療分野で研究職として働きたいと思っています。
高いモチベーションを保ち、粘り強く研究に取り組んでほしい
小林さんは研究意欲が高く、自分で研究を進めていく力のある学生です。失敗から学べることもたくさんあるので、ちょっとした変化も見逃さずに取り組んでくれたらと思います。


生命・生物工学科
日下部 りえ 准教授
- ※この学びのスタイルは2023年度のものです。


理工学研究科 化学生命工学専攻
生命・生物工学分野 博士課程前期課程 1年次生
東山 侑加
研究テーマ
GP96阻害剤の探索


従来の抗菌薬に代わる治療薬開発が目標
GP96というタンパク質をブロックする化合物の探索を行っています。GP96を阻害することで肺炎球菌が気道の細胞に定着しにくくなり、インフルエンザ誘発性肺炎を予防することができます。従来の抗菌薬が効きにくい菌の出現が問題となっている現在、新たな治療薬の開発をめざして他大学と共同研究を行っています。
失敗の原因を探り、問題解決の道筋を考える
有機合成による化合物探索では、より効果が高くなるように官能基や構造の変換を行っています。失敗することも多いのですが、失敗した原因を掘り下げることで、何が課題なのかを把握し、解決方法を考えられるようになりました。大学院に進学した現在もこの研究を継続しており、将来は研究職として働きたいと考えています。
東山さんの時間割(学部2年次の秋学期履修科目)


- ※この学びのスタイルは2022年度のものです。


生命・生物工学科
2022年3月卒業
森田 凌世
研究テーマ
海藻中ヨウ素分子種の特定


生体利用に影響する分子形態を調べる
昆布やひじき、のりといった日本人に身近な海藻は、他の食品の数万倍ものヨウ素を含んでいます。しかし海藻から摂取したヨウ素の吸収率は、元の約半分にとどまることが先行研究によって分かりました。生体利用にも影響する海藻中ヨウ素については解明されていないことが多くあるため、私たちの研究ではヨウ素の分子形態に注目し、ヨウ素化合物の存在比を調べました。
ヨウ素化合物の種類と比率を明らかに
ヨウ素化合物の存在比を調べるために、HPLC(高速液体クロマトグラフィー)、ICP-MS(誘導結合プラズマ質量分析法)といった機器を用いて、液体中に含まれる化合物を分離・検出しデータ化。これによって海藻の種類ごとに含まれるヨウ素化合物の種類や比率を明らかにしています。
- ※この学びのスタイルは2021年度のものです。


理工学研究科 化学生命工学専攻
2021年3月修了
田村 和也
研究テーマ
新規乳酸菌由来アスパラギナーゼの機能解析と応用利用


新たな酵素の応用利用を妨げる原因を探る
大腸菌由来のアスパラギナーゼという酵素は、急性リンパ性白血病の治療薬として実用化されています。所属する研究室が全ゲノム解析に成功した乳酸菌のアスパラギナーゼは、既存の酵素よりも高い治療効果が期待されることがわかりました。しかし血中で失活し抗がん作用を発揮できないことが、医薬品への応用利用の妨げとなることが分かりました。
実験レベルではがん細胞の増殖抑制を確認
原因を探った結果、鉄イオンが酵素分子中の特定のアミノ酸と結合し、酵素を失活させていることが分かりました。そこで、遺伝子組み換えによって別のアミノ酸に置き換えた変異型酵素を作製し、培地中でがん細胞の増殖抑制が認められる段階まで研究を進めています。
- ※この学びのスタイルは2021年度のものです。


生命・生物工学科
4年次生
田中 元稀
研究テーマ
ホタテガイ副次産物を原料とした油脂の摂取による脂質代謝改善効果の評価


研究室発「ホタテオイル」の有用性評価に挑戦
日本で年に約23万トン水揚げされるホタテガイ。その加工の際、中腸腺といわれる内臓部分には有害物質が含まれているため、従来は有償で処分され、廃棄されてきました。しかしこの部分に含まれる脂質は、オメガ3脂肪酸という健康に有用な成分を豊富に含んでいます。2016年、研究室の先生と先輩たちの研究グループが、有害物質を除去して食品規格を満たすホタテオイルを作り出すことに成功しました。私は現在、ホタテオイルに含まれるオメガ3脂肪酸に、脂質代謝を改善する効果があるかどうかを評価する研究を行っています。
食品をテーマにした研究で大学院に進学を希望
食品をテーマにした研究を始めたきっかけは、自分が小さい頃から「おじいちゃん子」だったことにあります。最近、体が弱ってきたのに病院に行くのを嫌がる様子を見ているうちに、食品の方からアプローチができないかと考えるようになりました。卒業後は大学院修士課程に進み、3年間の研究生活を経験したのちに、食品関連企業で研究職に就きたいと考えています。
- ※この学びのスタイルは2020年度のものです。


理工学研究科 化学生命工学専攻
博士課程前期課程 1年次生
高橋 葵
研究テーマ
バイオエタノール生産に適した酵母の非組換え育種


生産性向上につながる酵母を非遺伝子組換えで創る
バイオエタノールは、石油などの化石資源を節約するための代替燃料として脚光を浴びています。しかしその生産効率には改善の余地があり、いかに生産エネルギーとコストを抑えるかが今後の課題です。私は、生産時にグルコースをエタノールに変換する酵母について研究中。熱とエタノールの両方に高い耐性をもつ酵母を、非遺伝子組換えで創り出すことをめざしています。
大学院に進学して研究を続け、
社会と環境に貢献できる人材をめざす
3年次秋学期から研究室で研究を始めたのですが、最初は耐性の評価基準も手探りの状態でした。しかし仮説立案と実験による検証を重ねた結果、有効な評価方法が見えつつあります。今後は大学院に進学して、評価の精緻化を進めるとともに、バイオエタノール生産に適した新たな酵母の育種にも挑戦できたらと思います。将来、化学メーカーなどで環境に貢献できるモノづくりに携われるよう、引き続き研究を続けます。
- ※この学びのスタイルは2019年度のものです。


理工学研究科 化学生命工学専攻
博士課程前期課程 1年次生
降籏 和樹
研究テーマ
ヒストン脱アセチル化酵素(HDAC)6選択的阻害剤の探索研究


がんを進行させるタンパク質を狙い撃ちする化合物を探索
タンパク質のひとつであるHDAC6にはがんを進行させる作用があります。HDAC6を阻害する化合物の研究に取り組みました。すでに先行研究が進められていますが、効果が不十分なため実用化されずにいます。そこで私は、安定した効果を得るため、先輩が考えた分子結合モデルを用いて元素を入れ替える実験を1年かけて行いました。現在は、阻害活性の評価を専門機関へ依頼し、その結果を待っているところです。
さらに研究の幅を広げるため、大学院へ進学
将来は研究開発職を志望。研究する上で必要とされる、実験手法の開発や結果分析といった思考力を鍛えるため、大学院への進学を決めました。4年次に大学院の授業を受ける機会があり、製薬会社の研究員の方から開発にまつわる秘話を聞くなど、とても刺激を受けました。大学で研究したHDAC6阻害剤はアトピー性疾患への効果も期待されています。大学院での高度な研究を通して実用化の一翼を担えるように頑張りたいと思います。
- ※この学びのスタイルは2018年度のものです。


理工学研究科 化学生命工学専攻
博士課程前期課程 2年次生
安田 真央
研究テーマ
微生物の生理活性物質生合成機構の解析とそれを応用した新規創薬リード化合物の創生

近年、薬剤耐性菌の出現が医薬品開発の障壁となっています。そうした医薬品化合物の生成過程を分子レベルで解明し、遺伝子組み換え技術によりその機構を自在に改変することで、新たな生理活性物質の創生が可能となり、さらに、その手法は将来の医療を支える重要な技術となり得ます。科学技術の進歩により、遺伝子の解読は容易に行えるようになりました。しかし、複数の遺伝子を狙ったとおり細胞から取り出し、設計どおりに改変して化合物を作らせることは容易ではなく、数カ月を要します。私は、それを1〜2週間程度に短縮した新たな遺伝子工学技術の開発を進めています。この手法が確立できれば、新しい化合物を簡単に作り出せるようになり、新薬の創生にもつながります。また、世界中の人が活用し、後世に残る可能性もあるため、やる気がみなぎります。将来は、研究職に就き、大学で培った能力を発揮したいと思います。
前例のない研究テーマにチャレンジ。失敗を繰り返すことで課題解決能力が養われます。
生命科学分野の多くは、医薬品をはじめ、世の中の役に立つものを作り出す、最先端の研究であふれています。前例のないテーマだからこそ、研究に費やす時間の9割は失敗です。そこから問題点を導き出し、解決策を考えながら進めることが大切で、社会に出て必要となる課題解決能力が磨かれます。自らの可能性を試したい人はぜひチャレンジしてください。


生命・生物工学科
山中 一也 准教授
- ※この学びのスタイルは2017年度のものです。


理工学研究科 化学生命工学専攻
博士課程前期課程 1年次生
荒西 佳織
研究テーマ
石クラゲ(Nostoc commune)の培養方法の改善と吸水性ポリマーの生産




道端にも群生する石クラゲの培養方法、生態、活用方法について調べています。石クラゲはラン藻類の仲間で、水を吸うとふくれ、乾燥すると縮むのが大きな特徴。吸水性ポリマーの新素材として、また紫外線カットの機能を化粧品などに活かせるなどの可能性を秘めています。難点は、量産しにくいこと。湿度、温度、培地の成分などさまざまな条件を試しても、増え方が変わりません。先生から励まされ、関連する海外の論文から情報を探るうち、赤い光を照射するというヒントを得ました。すると従来は1.2倍だった増え方が、3倍以上に。実験開始から約半年が経過しており、思わず先生と「シャーレを見てください!」「すごい、まったく違う! 」と喜びを分かちあいました。自分で考えて、諦めずに道を切り拓く大切さを実感できた瞬間です。今はこの成果を学会で発表する準備をしています。現在は大学院に進学し、吸水性、紫外線カットなどの機能について追究しています。ゆくゆくは食品や化粧品といったメーカーで、研究の成果を活かすことが目標です。
天然植物由来物質への評価が、見直されています。10年後の社会を見据えて「次」を考えましょう。
医薬品などに使われる物質は、従来の有機合成から天然植物由来へと移行しつつあります。このように社会の価値観や私たちが創造すべき対象は、常に変遷するもの。大学時代に変化への対応力を鍛えておくことは、大変有意義です。私の研究室では、学生一人につきワンテーマ。それぞれ1~3社程度の企業と産学連携で研究しています。10年後の社会に役立つテーマにトライしましょう。


生命・生物工学科
河原 秀久 教授
- ※この学びのスタイルは2016年度のものです。


理工学研究科 化学生命工学専攻
博士課程前期課程 2年次生
柄澤 歩
研究テーマ
乳酸菌Lactococcus lactisの高密度培養によるナイシン生産

ヨーグルトなどの身近な発酵食品に含まれる乳酸菌は、人に良い影響を与える微生物です。また、抗菌作用があるナイシンのように、乳酸菌から作ることができる有用物質も数多くあります。私は、大量生産への社会的要請に応え、企業との共同で乳酸菌を効率よく増やす研究に取り組んでいます。乳酸菌は通常、増えるときに乳酸を生成します。しかし、できてしまった乳酸は乳酸菌の増殖を邪魔する方向に働くので、増える上限が決まってしまいます。そこで私は、乳酸を作らせないようにすれば、効率的に乳酸菌が増えるのではと考えました。自然界では、乳酸菌は腐った木など、液体分が40-50%しかない環境下で増殖するので、実験室でも同程度まで水分を減らした培地を作り、そのなかで乳酸菌を培養。その結果、通常よりも活発に増殖することが確認できました。従来は、乳酸ができるのは当然で、仕方がないと考えられていました。その「当たり前」を疑うという発想が面白く、研究にやりがいを感じています。
豊かな食文化が生み出した発酵工学のさらなる発展を期待しています。
近年、遺伝子工学の隆盛と裏腹に、伝統的な発酵工学を深く学べる研究室は少なくなりました。しかし、日本酒、味噌など豊富な発酵食品の文化をもつ日本は、この分野の研究では世界をリードしています。研究室では、今までにない乳酸菌の製造法を開発しようとしている柄澤さんのような、発酵生産の基礎を身につけて新しいテーマに挑む学生を育てていきたいと考えています。


生命・生物工学科
片倉 啓雄 教授
- ※この学びのスタイルは2015年度のものです。


理工学研究科 ライフ・マテリアルデザイン専攻(現 化学生命工学専攻)
博士課程前期課程 2年次生
大塚 錬
研究テーマ
ヘモグロビン摂取による脂質代謝改善効果




食物にはまだ解明されていない、数多くの機能が秘められています。そうした可能性を、分析と動物実験から追究していくのが私の研究です。研究対象は、私たちの赤血球にも存在するヘモグロビン。一般的に、不足すると貧血の原因になることで知られていますが、これをマウスに与えると血液中の中性脂肪が大きく減少することがわかりました。その結果に着目し、ヘモグロビンが脂質代謝に働く役割について解明を進めています。まずは、ヘモグロビンを構成するどの成分が働くのかを明らかにするため、現在はヘムとグロビンを分離させる作業が中心。離した成分をマウスの餌に加え、1カ月の飼育後に臓器の変化を調べていくという手法です。過去の事例や参考文献も少ないため、いまはまだ手探り状態の研究が続いていますが、学んだ理論と実験の結果が重なり、頭に描いていたイメージが具現化できたとき、自分の研究が着実に前進しているんだという喜びを感じます。病気の治療や体質の改善のため、食生活を制限される人が多いなか、新たな食の可能性を広げることで「食べる楽しみ」を社会の皆さんに届けたいと思います。
水産食品とミネラルの双方向から、食品がもつ真の機能を解明します。
「水産食品の機能性」と「ミネラルの栄養学」の双方向から、食と栄養に迫るのが本研究室の特徴。分析と評価を重ねて食品の機能を解き明かし、間違った世間の常識に警鐘を鳴らしています。大塚さんはあらゆる難題にも真摯に取り組むことで、自分なりの答えを導く力を磨いてきました。研究活動で育んだ自主性を、社会でも発揮してくれると期待しています。


生命・生物工学科
福永 健治 教授
- ※この学びのスタイルは2014年度のものです。













